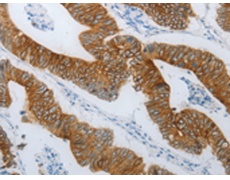
一抗

|
Background: |
May function as a regulator of the EGFR pathway. Probable tumor suppressor which may function in cell growth, proliferation and adhesion. |
|
Applications: |
ELISA, IHC |
|
Name of antibody: |
TMEM8B |
|
Immunogen: |
Synthetic peptide of human TMEM8B |
|
Full name: |
Transmembrane protein 8B |
|
Synonyms: |
NGX6, NAG-5, C9orf127, RP11-112J3.10 |
|
SwissProt: |
A6NDV4 |
|
ELISA Recommended dilution: |
1000-5000 |
|
IHC positive control: |
Human colon cancer and Human gastric cancer |
|
IHC Recommend dilution: |
25-100 |

 購物車
購物車 幫助
幫助
 021-54845833/15800441009
021-54845833/15800441009